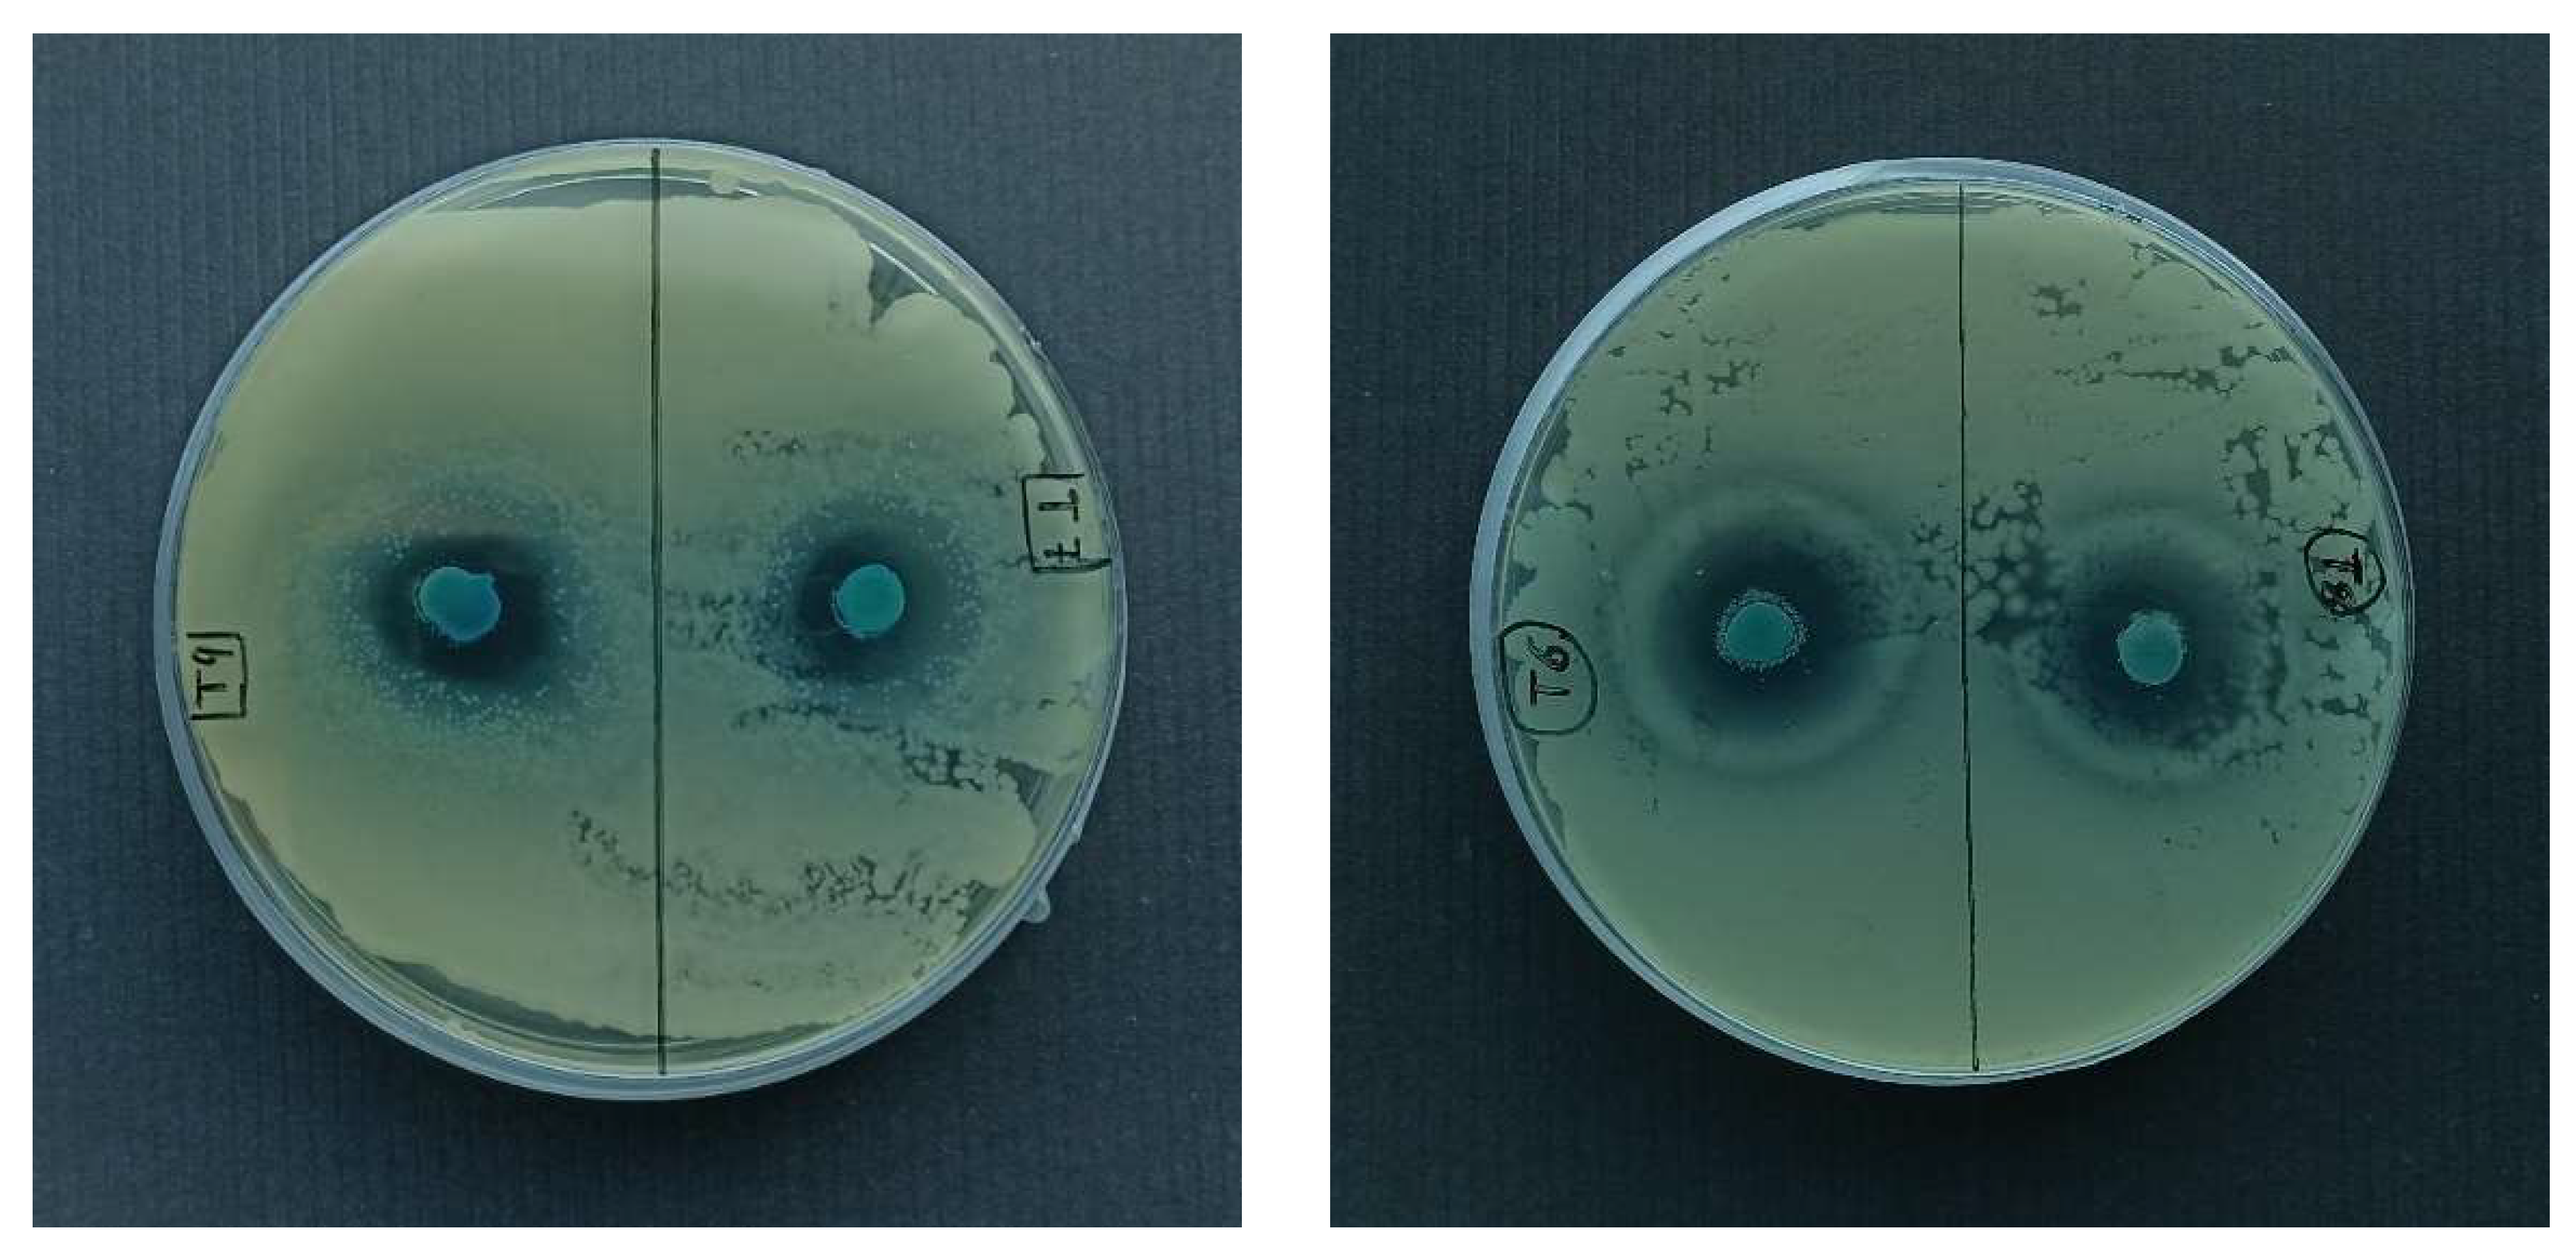
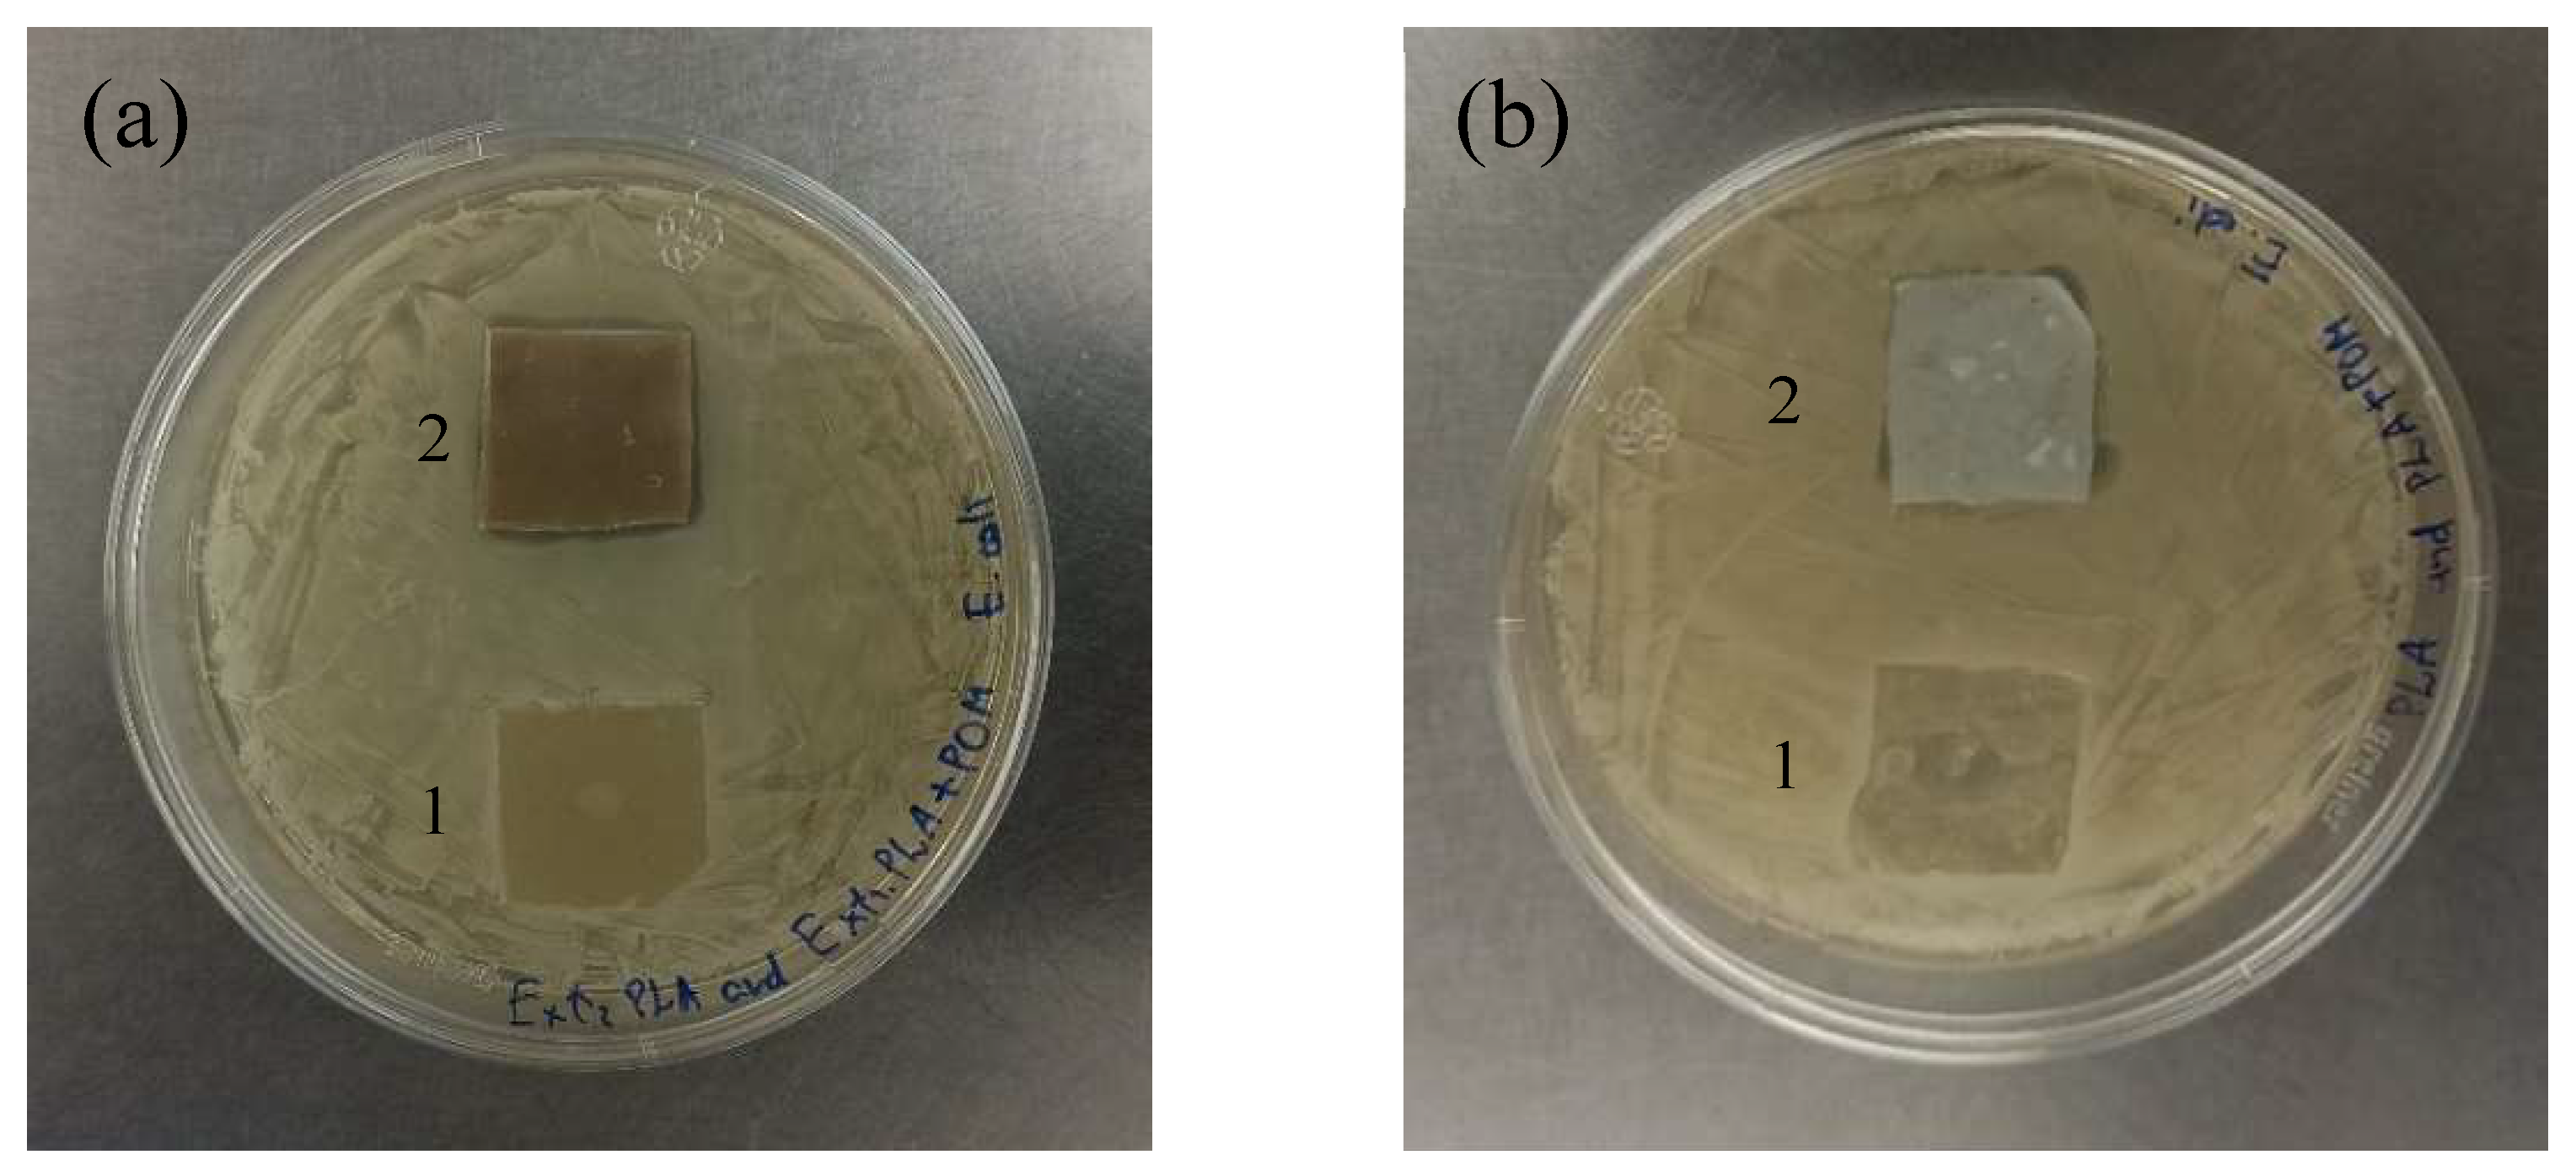

Development of Functional Composite Cu(II)-Polyoxometalate/PLA with Antimicrobial Properties
Abstract
1. Introduction
2. Results and Discussion
2.1. Characterization of POM
2.2. Preparation and Characterization of PLA Composite Films
2.2.1. FT-IR of Characterization of PLA Composite Films
2.2.2. Thermal Properties
2.3. Copper(II) Ion Release Studies
2.3.1. Copper(II) Ion Release from Air-Dried POM
2.3.2. Copper(II) Ion Release from PLA Composite Films
2.4. Antimicrobial Properties of POM and PLA Composite Films
3. Materials and Methods
3.1. Materials
3.2. Synthesis of POMs
3.3. Preparation of PLA Composite Films
3.3.1. The Solvent Casting Method
3.3.2. The Melt Extrusion Method
3.4. Copper(II) Ion Release Studies
3.4.1. Copper(II) Ion Release Studies from POM
3.4.2. Copper(II) Ion Release Studies from Composite PLA Films
3.5. Analytical Methods
3.5.1. Scanning Electron Microscopy (SEM)
3.5.2. Fourier Transform Infrared Spectroscopy (FT-IR) of PLA Composite Films
3.5.3. Thermal Characterization of PLA Composite Films
3.5.4. Mass Spectrometry
3.6. Antimicrobial Studies
3.6.1. Antimicrobial Properties of POMs and Determination of MBC
3.6.2. Antimicrobial Properties of PLA Composite Films
4. Conclusions
Supplementary Materials
Author Contributions
Funding
Data Availability Statement
Acknowledgments
Conflicts of Interest
Sample Availability
References
- Hunt, A.J.; Farmer, T.J.; Clark, J.H. Elemental Sustainability and the Importance of Scarce Element Recovery. Elem. Recovery Sustain. 2013, 22, 1–28. [Google Scholar]
- Kananovich, D.G. Copper-Catalyzed Trifluoromethylation Reactions. Copp. Catal. Org. Synth. 2020, 367–393. [Google Scholar] [CrossRef]
- Casey, A.L.; Adams, D.; Karpanen, T.J.; Lambert, P.A.; Cookson, B.D.; Nightingale, P.; Miruszenko, L.; Shillam, R.; Christian, P.; Elliott, T.S.J. Role of copper in reducing hospital environment contamination. J. Hosp. Infect. 2010, 74, 72–77. [Google Scholar] [CrossRef] [PubMed]
- Schmidt, M.G. The role of antimicrobial surfaces in hospitals to reduce healthcare-associated infections (HAIs). Decontam. Hosp. Healthc. 2020, 259–299. [Google Scholar] [CrossRef]
- Kingston, D.; Noble, W.C. Tests on self-disinfecting surfaces. J. Hyg. Camb. 1964, 62, 519–531. [Google Scholar] [CrossRef] [PubMed]
- Li, X.; Guo, C.; Liu, X.; Liu, L.; Bai, J.; Xue, F.; Lin, P.; Chu, C. Impact behaviors of poly-lactic acid based biocomposite reinforced with unidirectional high-strength magnesium alloy wires. Prog. Nat. Sci. Mater. Int. 2014, 24, 472–478. [Google Scholar] [CrossRef]
- Okamoto, M.; John, B. Synthetic biopolymer nanocomposites for tissue engineering scaffolds. Prog. Polym. Sci. 2013, 38, 1487–1503. [Google Scholar] [CrossRef]
- Bruna, J.E.; Quilodrán, H.; Guarda, A.; Rodríguez, F.; Galotto, M.J.; Figueroa, P. Development of antibacterial MtCu/PLA nanocomposites by casting method for potential use in food packaging. J. Chil. Chem. Soc. 2015, 60, 3009–3014. [Google Scholar] [CrossRef]
- Kostic, D.; Vukasinovic-Sekulic, M.; Armentano, I.; Torre, L.; Obradovic, B. Multifunctional ternary composite films based on PLA and Ag/alginate microbeads: Physical characterization and silver release kinetics. Mater. Sci. Eng. C 2019, 98, 1159–1168. [Google Scholar] [CrossRef]
- Mohammadi, M.S.; Ahmed, I.; Muja, N.; Rudd, C.D.; Bureau, M.N.; Nazhat, S.N. Effect of phosphate-based glass fibre surface properties on thermally produced poly(lactic acid) matrix composites. J. Mater. Sci. Mater. Med. 2011, 22, 2659–2672. [Google Scholar] [CrossRef]
- Longano, D.; Ditaranto, N.; Cioffi, N.; Di Niso, F.; Sibillano, T.; Ancona, A.; Conte, A.; Del Nobile, M.A.; Sabbatini, L.; Torsi, L. Analytical characterization of laser-generated copper nanoparticles for antibacterial composite food packaging. Anal. Bioanal. Chem. 2012, 403, 1179–1186. [Google Scholar] [CrossRef] [PubMed]
- Dasaria, A.; Quirósb, J.; Herreroa, B.; Boltesb, K.; García-Calvoc, E.; Rosal, R. Antifouling membranes prepared by electrospinning polylactic acid containing biocidal nanoparticles. J. Membr. Sci. 2012, 405–406, 134–140. [Google Scholar] [CrossRef]
- Vergara-Figueroa, J.; Martin, S.A.; Cerda-Leal, F.; Gacitúa, W. Dual electrospinning of a nanocomposites biofilm: Potential use as an antimicrobial barrier. Mater. Today Commun. 2020, 25, 101671. [Google Scholar] [CrossRef]
- Rhule, J.T.; Hill, C.L.; Judd, D.A. Polyoxometalates in Medicine. Chem. Rev. 1998, 98, 327–357. [Google Scholar] [CrossRef]
- Tanuhadi, E.; Kampatsikas, I.; Giester, G.; Rompel, A. Synthesis, characterization, and POM-protein interactions of a Fe-substituted Krebs-type Sandwich-tungstoantimonate. Mon. Chem. Chem. Mon. 2019, 150, 871–875. [Google Scholar] [CrossRef]
- Bijelic, A.; Aureliano, M.; Rompel, A. The antibacterial activity of polyoxometalates: Structures, antibiotic effects and future perspectives. Chem. Commun. 2018, 54, 1153–1169. [Google Scholar] [CrossRef]
- Qu, X.; Yang, Y.; Yu, X.; Lv, Z.; Ji, M.; Feng, S.-Y. A novel paradodecatungstate B compound decorated by transition metal copper, Na2Cu5(H2O)24(OH)2[H2W12O42]·10H2O: Synthesis, structure and antitumor activities. Inorg. Chem. Comm. 2015, 60, 126–130. [Google Scholar] [CrossRef]
- Yamase, T.; Fukuda, N.; Tajima, Y. Synergistic effect of polyoxotungstates in combination with beta-lactam antibiotics on antibacterial activity against methicillin-resistant Staphylococcus aureus. Biol. Pharm. Bull. 1996, 19, 459–465. [Google Scholar] [CrossRef]
- Fukuda, N.; Yamase, T.; Tajima, Y. Inhibitory Effect of Polyoxotungstates on the Production of Penicillin-binding Proteins and β-Lactamase against Methicillin-resistant Staphylococcus aureus. Biol. Pharm. Bull. 1999, 22, 463–470. [Google Scholar] [CrossRef][Green Version]
- Tajima, Y. Lacunary-Substituted Undecatungstosilicates Sensitize Methicillin-Resistant Staphylococcus aureus to β-Lactams. Biol. Pharm. Bull. 2001, 24, 1079–1084. [Google Scholar] [CrossRef][Green Version]
- Hasenknopf, B. Polyoxometalates: Introduction to a class of inorganic compounds and their biomedical applications. Front. Biosci. 2005, 10, 275–287. [Google Scholar] [CrossRef] [PubMed]
- Inoue, M.; Segawa, K.; Matsunaga, S.; Matsumoto, N.; Oda, M.; Yamase, T. Antibacterial activity of highly negative charged polyoxotungstates, K27[KAs4W40O140] and K18[KSb9W21O86], and Keggin-structural polyoxotungstates against Helicobacter pylori. J. Inorg. Biochem. 2005, 99, 1023–1031. [Google Scholar] [CrossRef] [PubMed]
- Tajima, Y.; Nagasawa, Z.; Tanabe, I.; Kusaba, K.; Tadano, J. Possible Mechanism of Action of β-Lactam-Enhancing Factor on Methicillin-Resistant Staphylococcus aureus. Microbiol. Immunol. 1994, 38, 639–648. [Google Scholar] [CrossRef] [PubMed]
- Tajima, Y. The Sensitizing Effects of Undecatungstocobalto(II)silicate on Methicillin-Resistant Staphylococcusaurens to β-Lactams. Biomed. Res. 2002, 23, 115–125. [Google Scholar] [CrossRef]
- Chen, S.; Wu, G.; Long, D.; Liu, Y. Preparation, characterization and antibacterial activity of chitosan–Ca3V10O28 complex membrane. Carbohydr. Polym. 2006, 64, 92–97. [Google Scholar] [CrossRef]
- Fukuda, N.; Yamase, T. In Vitro Antibacterial Activity of Vanadate and Vanadyl Compounds against Streptococcus pneumoniae. Biol. Pharm. Bull. 1997, 20, 927–930. [Google Scholar] [CrossRef]
- Inoue, M.; Suzuki, T.; Fujita, Y.; Oda, M.; Matsumoto, N.; Yamase, T. Enhancement of antibacterial activity of β-lactam antibiotics by [P2W18O62]6−, [SiMo12O40]4−, and [PTi2W10O40]7− against methicillin-resistant and vancomycin-resistant Staphylococcus aureus. J. Inorg. Biochem. 2006, 100, 1225–1233. [Google Scholar] [CrossRef]
- Radio, S.V.; Melnik, N.A.; Ivantsova, E.S.; Baumer, V.N. Crystal structure of double sodium-copper(II) paratungstate B: Na2Cu3(CuOH)2[W12O40(OH)2]·32H2O. J. Struct. Chem. 2014, 55, 879–886. [Google Scholar] [CrossRef]
- Kong, Q.-J.; Zhang, C.-J.; Chen, Y.-G. Synthesis, structure and characterization of three highly-connected 3D inorganic compounds based on paradodecatungstate-B. J. Mol. Struct. 2010, 964, 82–87. [Google Scholar] [CrossRef]
- Duvanova, E.S.; Mariichak, A.Y.; Baumer, V.N.; Rozantsev, G.M.; Radio, S.V. Crystal structure of double sodium–copper(II) paratungstate B, Na2Cu4[W12O40(OH)2]·22H2O, and mixed copper(II) paratungstate B–hydroxide, Cu5[W12O40(OH)2]·2Cu(OH)2·30H2O. J. Struct. Chem. 2021, 62, 379–389. [Google Scholar] [CrossRef]
- Righetti, M.C.; Gazzano, M.; Di Lorenzo, M.L.; Androsch, R. Enthalpy of melting of α′- and α-crystals of poly(l-lactic acid). Eur. Polym. J. 2015, 70, 215–220. [Google Scholar] [CrossRef]
- Jacob, M.E.; Fox, J.T.; Nagaraja, T.G.; Drouillard, J.S.; Amachawadi, R.G.; Narayanan, S.K. Effects of Feeding Elevated Concentrations of Copper and Zinc on the Antimicrobial Susceptibilities of Fecal Bacteria in Feedlot Cattle. Foodborne Pathog. Dis. 2010, 7, 643–648. [Google Scholar] [CrossRef] [PubMed]
- Ren, G.; Hu, D.; Cheng, E.W.C.; Vargas-Reus, M.A.; Reip, P.; Allaker, R.P. Characterisation of copper oxide nanoparticles for antimicrobial applications. Int. J. Antimicrob. Agents 2009, 33, 587–590. [Google Scholar] [CrossRef] [PubMed]
- Azlin-Hasim, S.; Cruz-Romero, M.C.; Cummins, E.; Kerry, J.P.; Morris, M.A. The potential use of a layer-by-layer strategy to develop LDPE antimicrobial films coated with silver nanoparticles for packaging application. J. Colloid Interface Sci. 2016, 461, 239–248. [Google Scholar] [CrossRef]
- Rosenberg, M.; Visnapuu, M.; Vija, H.; Kisand, V.; Kasemets, K.; Kahru, A.; Ivask, A. Selective antibiofilm properties and biocompatibility of nano-ZnO and nano-ZnO/Ag coated surfaces. Sci. Rep. 2020, 10, 1–15. [Google Scholar] [CrossRef]
- Lim, E.S.; Koo, O.K.; Kim, M.-J.; Kim, J.-S. Bio-enzymes for inhibition and elimination of Escherichia coli O157:H7 bioflm and their synergistic efect with sodium hypochlorite, Sci. Rep. 2019, 9, 13478. [Google Scholar] [CrossRef]
- Lemire, J.A.; Harrison, J.J.; Turner, R.J. Antimicrobial activity of metals: Mechanisms, molecular targets and applications. Nat. Rev. Microbiol. 2013, 11, 371–384. [Google Scholar] [CrossRef]
- Gunawan, C.; Teoh, W.Y.; Marquis, C.P.; Amal, R. Cytotoxic origin of copper(II) oxide nanoparticles: Comparative studies with micron-sized particles, leachate, and metal salts. ACS Nano 2011, 5, 7214–7225. [Google Scholar] [CrossRef]
- Palza, H. Antimicrobial Polymers with Metal Nanoparticles. Int. J. Mol. Sci. 2015, 16, 2099–2116. [Google Scholar] [CrossRef]
- Damm, C.; Munstedt, H.; Rosch, A. The antimicrobial efficacy of polyamide 6/silver-nano- and microcomposites. Mater. Chem. Phys. 2008, 108, 61–66. [Google Scholar] [CrossRef]
- ISO 22196:2011(en); Measurement of Antibacterial Activity n Plastics and Other Non-Porous Surfaces. Available online: https://www.iso.org/standard/54431.html (accessed on 7 March 2022).
- JIS Z 2801:2000; Antibacterial Products—Test for Antibacterial Activity and Efficacy. Japan Standard Association: Tokyo, Japan, 2000. Available online: https://infostore.saiglobal.com/en-au/Standards/JIS-Z-2801-2000-634364_SAIG_JSA_JSA_1462706/ (accessed on 7 March 2022).

| Material Preparation Method | Antimicrobial Agent | Agent Content | Antimicrobial Activity | Ref. | |
|---|---|---|---|---|---|
| Solvent casting method | Copper modified montmorillonite (MtCu2+ and MtCu0) | 1, 3, and 5 wt.% | MtCu2+ against E. coli: 1 wt.% 3.68 log CFU mL–1 (99.97% reduction) 3 wt.% 5.64 log CFU mL–1 (99.99% reduction) 5 wt.% 5.75 log CFU mL–1 (99.99% reduction) | MtCu0 against E. coli: 1 wt.% 1.46 log CFU mL–1 (96.53% reduction) 3 wt.% 1.76 log CFU mL–1 (98.28% reduction) 5 wt.% 5.63 log CFU mL–1 (99.99% reduction) | [8] |
| Alginate microbeads containing silver nanoparticles (AgNPs) | 5 wt.% | Agar diffusion method results (inhibition zone diameter): 1–2 mm (E. coli) and 4 mm (S. aureus) | [9] | ||
| Poly lactic-b-4-vinylpyridine (PDLA-b-P4VP); Ag-nanoparticles | arbitrary | PLLA/PDLA255-P4VP46 against E. coli, 83.2% reduction; PLLA/PDLA255-P4VP46, 75, 98/Ag against E. coli, 100% reduction | [10] | ||
| Cu-nanoparticles | 0.3 wt.% | Activity against mix of P. fluorescens and P. putida: 6.0 log CFU·mL–1 (CuNPs-C-PLA), 7.4 log CFU·mL–1 (blank PLA) | [11] | ||
| Electrospinning method | Fibrillar particles of Ag-sepiolite and Cu-sepiolite | 5 wt.% | 35% (P. putida), 85% (S. cerevisiae) reduction | [12] | |
| Copper salt ion-exchange zeolite nanoparticles (nZH-Cu) | 1, 2, and 3 wt.% | PLA 1%, nZH-Cu 55.3% (S. aureus), and 62.7% (S. Typhi) reduction; PLA ≥2%, nZH-Cu 100% (S. aureus and S. Typhi) reduction | [13] | ||
| Sample | Weight (g) | Film Thickness (mm) | POM Particles Average Size (µm) | POM Particle Spacing (µm) |
|---|---|---|---|---|
| Extr. POM/PLA composite film | 0.215 ± 0.001 | 1.21 ± 0.04 | 0.75 ± 0.37 | 17 ± 9 |
| PLA+POM | 0.056 ± 0.006 | 0.17 ± 0.02 | 1.03 ± 0.48 | 11 ± 4 |
| Sample | Tm, °C | ΔHm, J/g | χc, % | Tg, °C |
|---|---|---|---|---|
| blank PLA film | 154 | 46.2 | 43 | 60 |
| POM/PLA film | 150 | 37.7 | 36 | 62 |
| blank Extr. PLA film | 171 | 43.2 | 40 | 60 |
| Extr. POM/PLA film | 164 | 37.5 | 36 | 59 |
| Sample | Temperature | Weight (g) | Film Thickness (mm) |
|---|---|---|---|
| Extr. POM/PLA | room temperature | 0.204 ± 0.001 | 1.195 ± 0.015 |
| 40 °C | 0.207 ± 0.001 | 1.245 ± 0.029 | |
| POM/PLA | room temperature | 0.047 ± 0.005 | 0.156 ± 0.005 |
| 40 °C | 0.049 ± 0.002 | 0.136 ± 0.013 |
| POM | T6 | T7 | T8 | T9 |
|---|---|---|---|---|
| Weight, g | 0.0518 | 0.0521 | 0.0520 | 0.0519 |
| Inhibition zone diameter, mm | 14 | 13 | 12 | 16 |
| Extr. PLA Film | Dilution Factor, D | Number of Colonies | The Number of Viable Cells (CFU·mL−1) | PLA Film | Dilution Factor, D | Number of Colonies | The Number of Viable Cells (CFU·mL−1) |
|---|---|---|---|---|---|---|---|
| Blank 1 | 102 | 247 | (2.45 ± 0.19) × 105 | Blank 1 | 103 | 59 | (6.13 ± 0.59) × 105 |
| Blank 2 | 225 | Blank 2 | 57 | ||||
| Blank 3 | 262 | Blank 3 | 68 | ||||
| Sample 1 | 101 | 121 | (1.39 ± 0.22) × 104 | Sample 1 | 101 | 38 | (4.1 ± 0.26) × 103 |
| Sample 2 | 164 | Sample 2 | 42 | ||||
| Sample 3 | 133 | Sample 3 | 43 |
Publisher’s Note: MDPI stays neutral with regard to jurisdictional claims in published maps and institutional affiliations. |
© 2022 by the authors. Licensee MDPI, Basel, Switzerland. This article is an open access article distributed under the terms and conditions of the Creative Commons Attribution (CC BY) license (https://creativecommons.org/licenses/by/4.0/).
Share and Cite
Duvanova, E.; Krasnou, I.; Krumme, A.; Mikli, V.; Radio, S.; Rozantsev, G.M.; Karpichev, Y. Development of Functional Composite Cu(II)-Polyoxometalate/PLA with Antimicrobial Properties. Molecules 2022, 27, 2510. https://doi.org/10.3390/molecules27082510
Duvanova E, Krasnou I, Krumme A, Mikli V, Radio S, Rozantsev GM, Karpichev Y. Development of Functional Composite Cu(II)-Polyoxometalate/PLA with Antimicrobial Properties. Molecules. 2022; 27(8):2510. https://doi.org/10.3390/molecules27082510
Chicago/Turabian StyleDuvanova, Ella, Illia Krasnou, Andres Krumme, Valdek Mikli, Serhii Radio, Georgiy M. Rozantsev, and Yevgen Karpichev. 2022. "Development of Functional Composite Cu(II)-Polyoxometalate/PLA with Antimicrobial Properties" Molecules 27, no. 8: 2510. https://doi.org/10.3390/molecules27082510
APA StyleDuvanova, E., Krasnou, I., Krumme, A., Mikli, V., Radio, S., Rozantsev, G. M., & Karpichev, Y. (2022). Development of Functional Composite Cu(II)-Polyoxometalate/PLA with Antimicrobial Properties. Molecules, 27(8), 2510. https://doi.org/10.3390/molecules27082510

